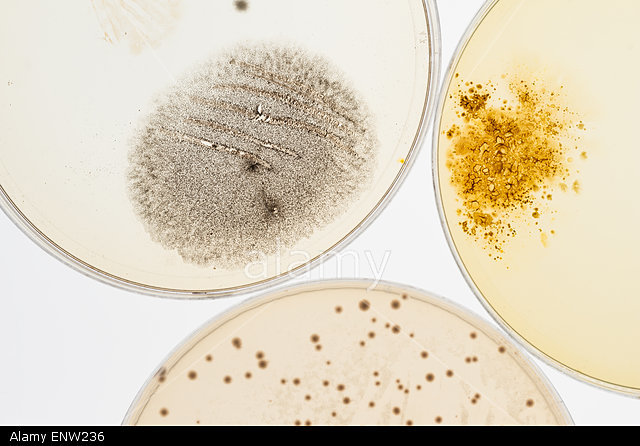
Agar Used to Grow Microbial Samples

-
English surgeon Edward Jenner creates a smallpox vaccine.
-
- Agriculture
- Fermentation (alcohol, cheese, vinegar, bread, etc)
- Cross breeding (mules)
-
-
Mendel researches pea plants and their traits. The beginning of understanding genetics.
-
-
-
Named by Heinrich Wilhelm Gottfried Von Waldeyer-Hartz
-
-
Term coined by Wilhelm Johannsen
-
Fly genome mapped by Alfred Sturtevant.
-
Discovered by American scientist Peyton Rous
-
The term "Biotechnology" was first used by Karl Erkey in 1919
-
-
Antibiotic (penicilling) discovered from mold in England by Alexander Fleming
-
-
-
Rosalind Franklin creates photographic evidence of DNA's structure.
-
- Watson and Crick build a model of DNA
-
-
Dr. Har Gobind Kohrana discovers a way to amplify synthesized DNA.
-
-
Frederick Sanger develops a process to sequence DNA more quickly.
-
-
FDA approves a human insulin drug created by Genentech and Eli Lilly using biotechnology
-
-
PCR (Polymerase Chain Reaction) discovered for amplifying DNA
-
Interferon is developed through biotechnology and is the first biotech developed anti-cancer drug.
-
-
-
Genome of Haemophilius influenzae sequenced.
-
First cloned mammal that was successfully born. Dolly was cloned by the scientist Ian Wilmut.
-
Chomosome 22 becomes the first human chromosome to be decoded
-
-
-
Proven by Craig Venter.
Want to make a timeline like this?
Use Timetoast to turn dates, events, milestones, and phases into a clear visual timeline you can build and share. Timetoast is a timeline maker for work, school, research, and stories.